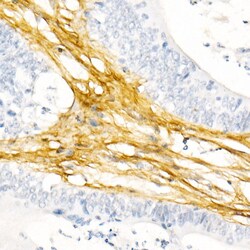
Invitrogen COL1A1 Recombinant Rabbit Monoclonal Antibody (8G5A3) 100 &mu;L;

missing translation for 'onlineSavingsMsg'
Learn More
Learn More
Invitrogen™ COL1A1 Recombinant Rabbit Monoclonal Antibody (8G5A3)


Rabbit Recombinant Monoclonal Antibody
Brand: Invitrogen™ MA551349
This item is not returnable.
View return policy
Description
Immunogen sequence: GKDGLNGLPG PIGPPGPRGR TGDAGPVGPP GPPGPPGPPG PPSAGFDFSF LPQPPQEKAH DGGRYYRADD ANVVRDRDLE VDTTLKSLSQ QIENIRSPEG.
The protein encoded by this gene is the pro-alpha1 chain of type I collagen whose triple helix comprises two alpha1 chains and one alpha2 chain. Type I is a fibril-forming collagen found in most connective tissues and is abundant in bone, cornea, dermis and tendon. Mutations in this gene are associated with osteogenesis imperfecta types I-IV, Ehlers-Danlos syndrome type VIIA, Ehlers-Danlos syndrome Classical type, Caffey Disease and idiopathic osteoporosis. Reciprocal translocations between chromosomes 17 and 22, where this gene and the gene for platelet-derived growth factor beta are located, are associated with a particular type of skin tumor called dermatofibrosarcoma protuberans, resulting from unregulated expression of the growth factor. Two transcripts, resulting from the use of alternate polyadenylation signals, have been identified for this gene.
Specifications
| COL1A1 | |
| Recombinant Monoclonal | |
| 1.1 mg/mL | |
| PBS with 0.05% BSA, 50% glycerol and 0.09% sodium azide; pH 7.3 | |
| P02452, P02454, P11087 | |
| COL1A1 | |
| synthetic peptide. | |
| 100 μL | |
| Primary | |
| Human, Mouse, Rat | |
| Antibody | |
| Liquid |
| ELISA, Immunohistochemistry (Paraffin), Western Blot, Immunocytochemistry | |
| 8G5A3 | |
| Unconjugated | |
| COL1A1 | |
| alpha-1 type 1 collagen; alpha-1 type I collagen; alpha1(I) procollagen; COL1A; Col1a1; Col1a-1; Cola1; Cola-1; COLIA1; Collagen 1; collagen alpha 1 chain type I; collagen alpha-1(I) chain; collagen alpha-1(I) chain preproprotein; Collagen I; collagen of skin, tendon and bone, alpha-1 chain; collagen type I alpha 1; collagen, type 1, alpha 1; collagen, type I, alpha 1; Collagen1A1; EDSC; Mov13; Mov-13; OI1; OI2; OI3; OI4; pro-alpha-1 collagen type 1; procollagen type I, alpha 1; procollagen, type 1, alpha 1; procollagen, type I, alpha 1; Type I Collagen; type I proalpha 1; type I procollagen alpha 1 chain; type I-alpha 1 collagen | |
| Rabbit | |
| Affinity chromatography | |
| RUO | |
| 1277, 12842, 29393 | |
| -20°C, Avoid Freeze/Thaw Cycles | |
| Liquid | |
| IgG |
Product Content Correction
Your input is important to us. Please complete this form to provide feedback related to the content on this product.
Product Title
Spot an opportunity for improvement?Share a Content Correction